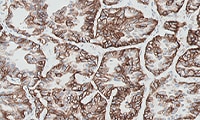
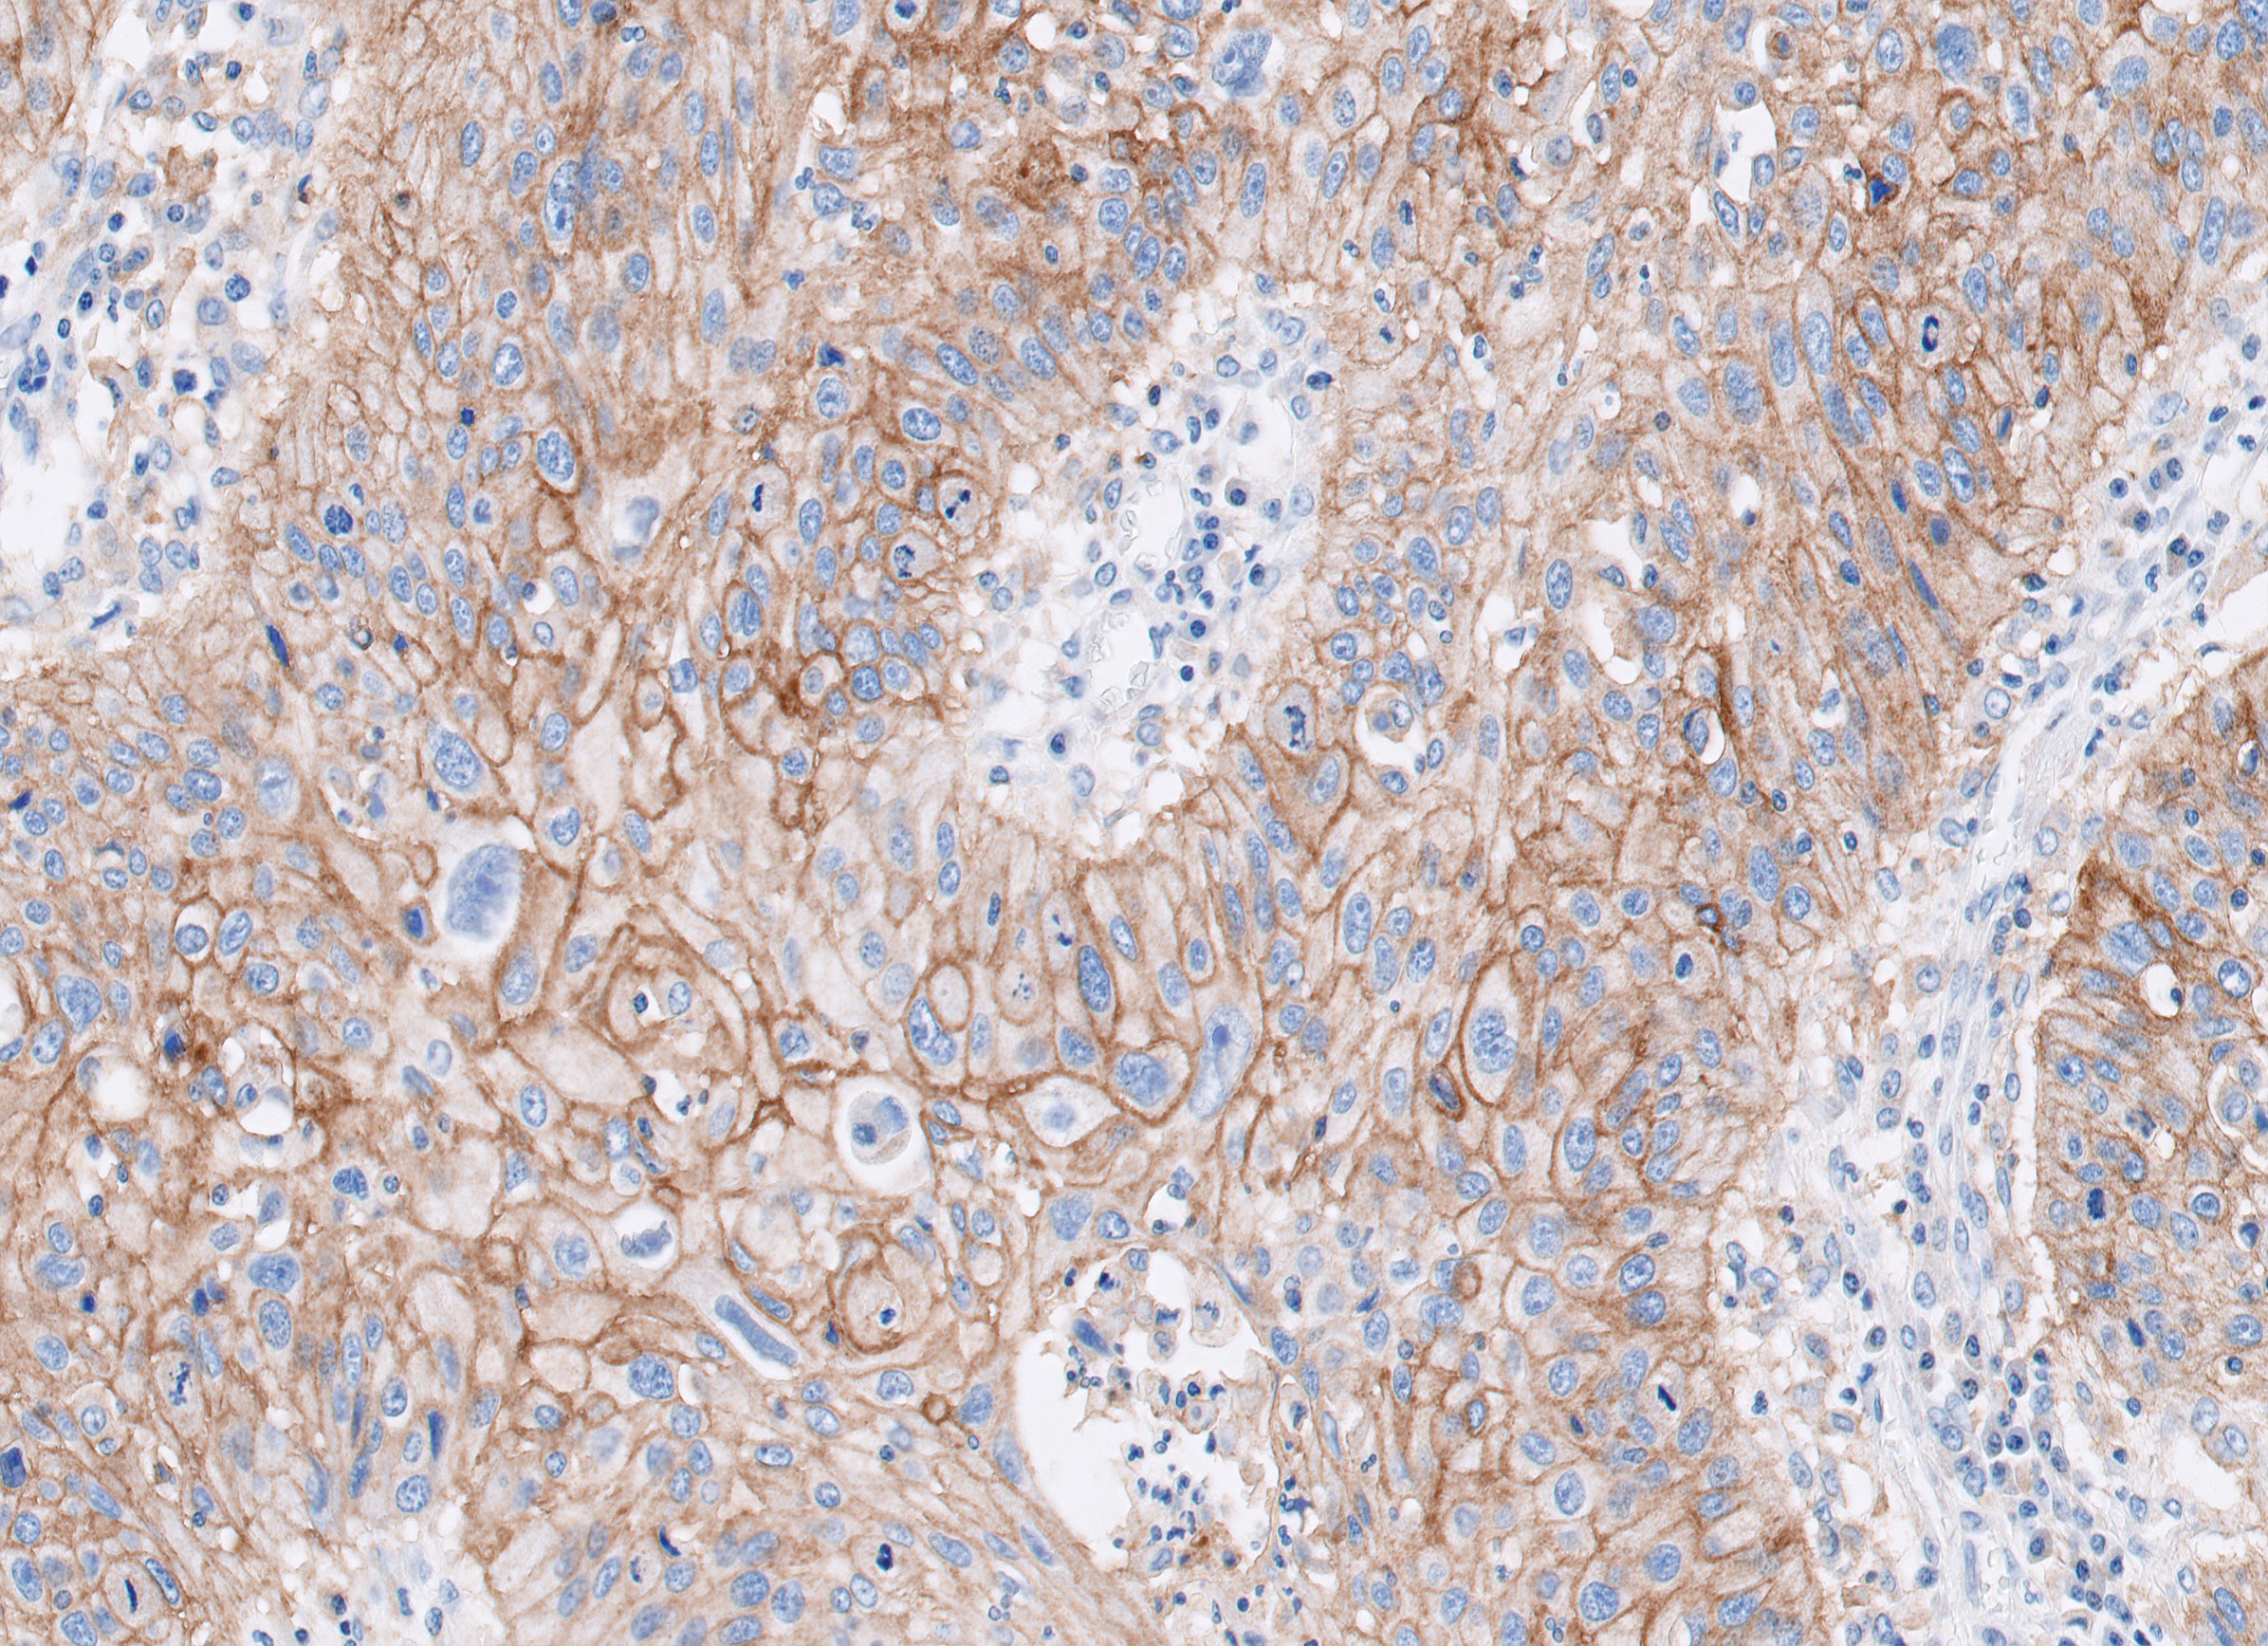

PD-L1 IHC 28-8 pharmDx「ダコ」結果判定オンライントレーニング


The PD-L1 IHC 28-8 pharmDx interpretation training is a comprehensive program with in-depth content and practice cases focused on helping pathologists to:
- Understand the role of immune checkpoint pathways
- Learn about technical considerations for optimal slide staining results
- Learn how to evaluate nsNSCLC, HNC, melanoma, gastric cancer, and esophageal cancer specimens stained with
PD-L1 IHC 28-8 pharmDx
Enhanced nsNSCLC (also suitable for NSCLC), HNC, melanoma, gastric cancer, and esophageal cancer training programs with virtual microscope for increased confidence in scoring PD-L1 stained slides.
Intended Use
To measure the proportion of PD-L1 expression in cancer tissue or cells
- Indication as an aid for proper administration of nivolumab [recombinant] in non-small cell lung cancer [NSCLC] patients,
head-and-neck cancer patients, gastric cancer patients, and esophageal cancer patients. - Indication as an aid for proper administration of nivolumab [recombinant] and ipilimumab [recombinant] combination in melanoma patients.
Important Basic Precautions
It is desirable to measure PD-L1 expression by PD-L1 IHC 28-8 pharmDx in determining whether or not the following drugs can be administered.
- Nivolumab [recombinant] for the patients with non-squamous NSCLC patients or head-and-neck cancer patients who have been treated with chemotherapy previously.
- Combination therapy of nivolumab [recombinant] and chemotherapy for NSCLC patients or gastric cancer patients who have not been treated with chemotherapy.
- Combination therapy including nivolumab [recombinant] for esophageal cancer patients who have not been treated
with chemotherapy. - Combination therapy of nivolumab [genetic recombinant] and ipilimumab [genetic recombinant] for melanoma patients and esophageal cancer patients.
If it is not possible to measure PD-L1 expression using PD-L1 IHC 28-8 pharmDx, refer to the packaging insert of the drugs, and appropriately judge the adequacy of administration.